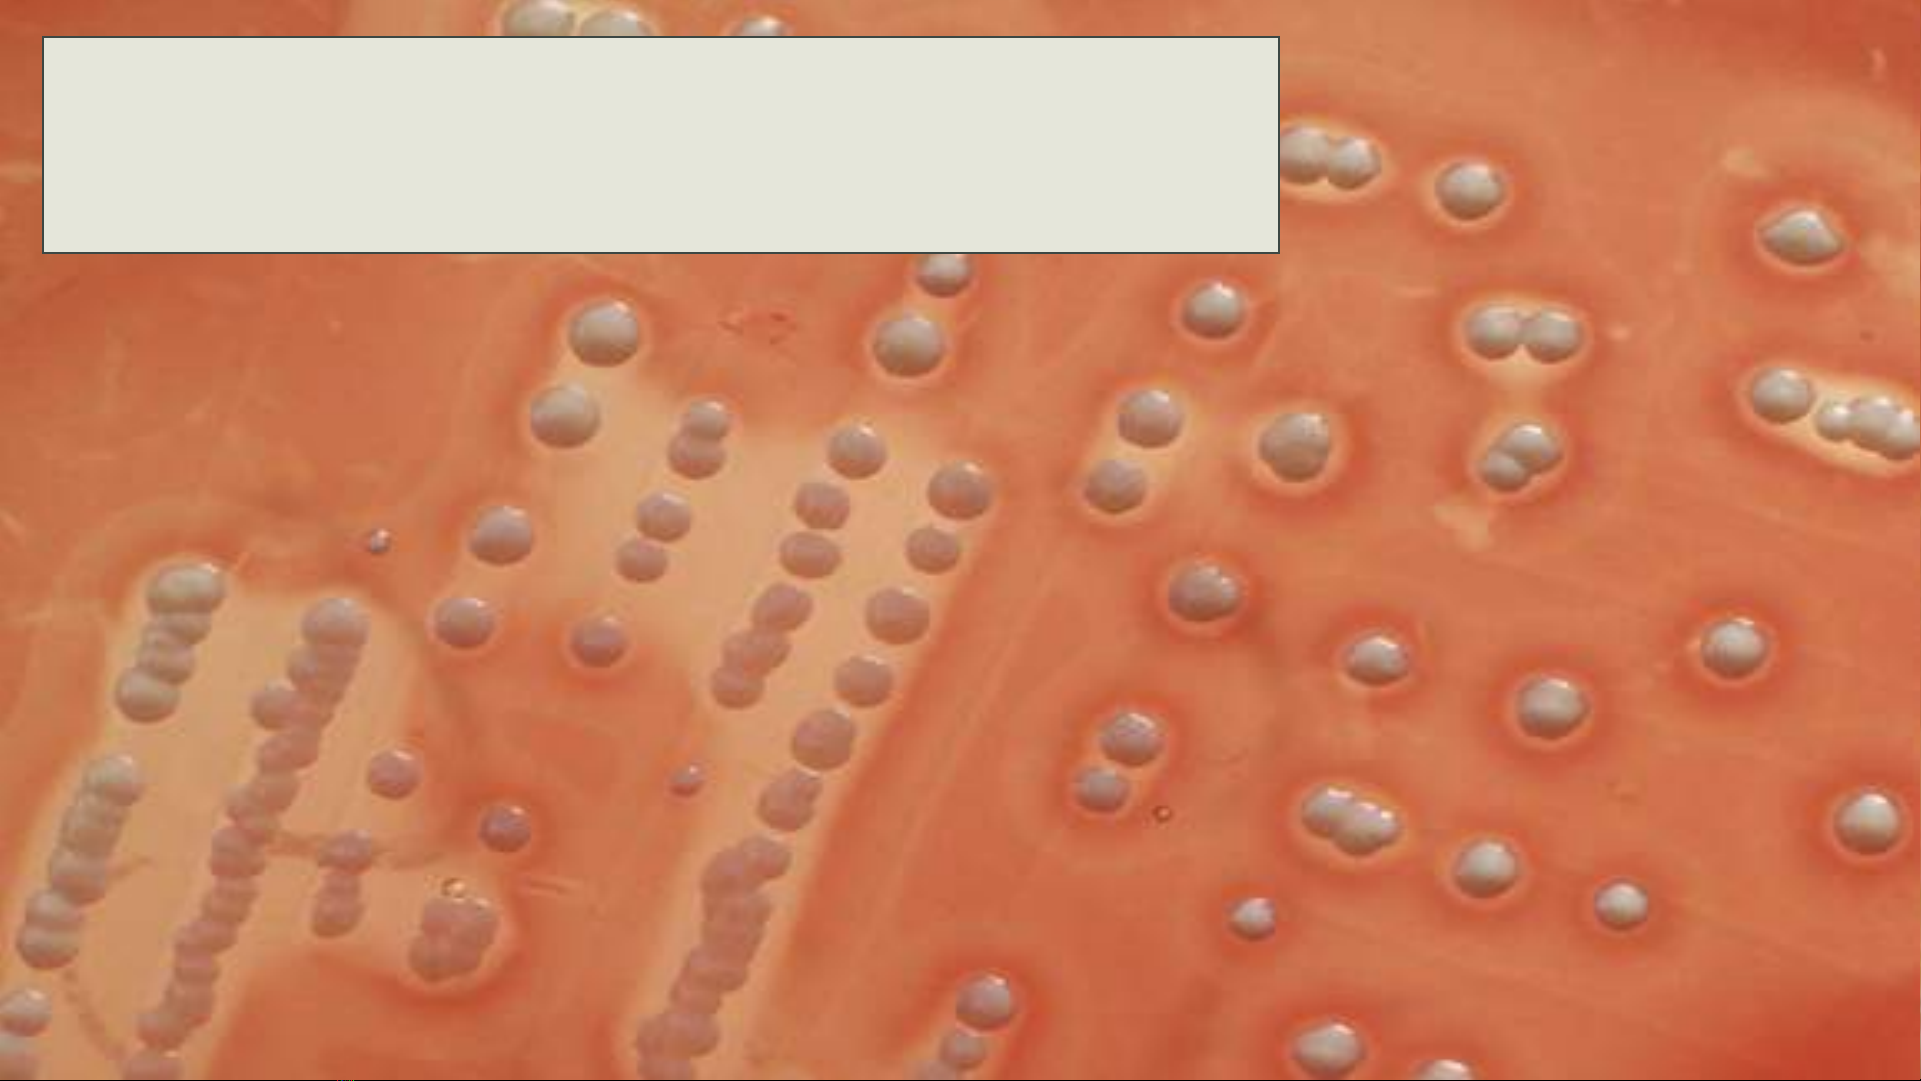

TIÊU CHUẨN KIỂM NGHIỆM
STAPHYLOCOCCUS AUREUS

Nội dung
1. Giới thiệu chung về S. aureus
2. Kiểm nghiệm S. aureus
§Phương pháp đếm khuẩn lạc
§Phương pháp MPN

Giới thiệu về
S. aureus
1. Lịch sử
2. Phân bố
3. Hình dạng tế bào
4. Điều kiện sinh trưởng
5. Đặc điểm sinh hóa
6. Khả năng gây bệnh

1. Lịch sử
§Staphylococcus được
Ogston phát hiện (1881)
trong vết thương có mủ.
§1884, Rosenbach tiếp
tục nghiên cứu.
Phân loại khoa học
Domain Bacteria
Regnum Eubacteria
Phylum Firmicutes
Class Bacilli
Ordo Bacillales
Familia Staphylococcaceae
Genus Staphylococcus
Species S. aureus
Những cụm khuẩn lạc S. aureus trong đĩa thạch
agar. Chú ý những vùng trống xung quanh các
cụm, là do sự phân giải hồng cầu trong thạch.

